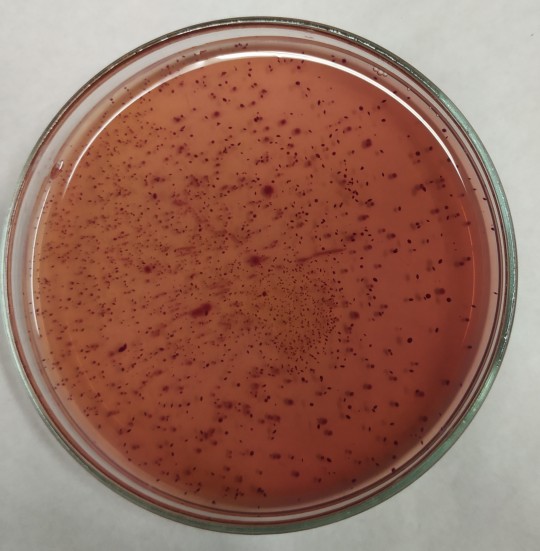
23. Růst na VČŽG
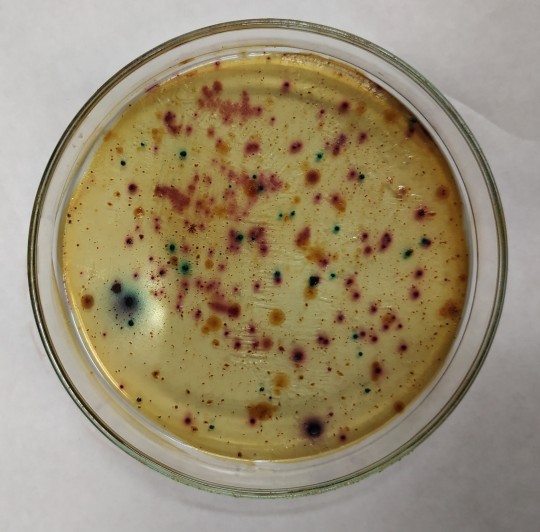
25. Růst na Chromocultu
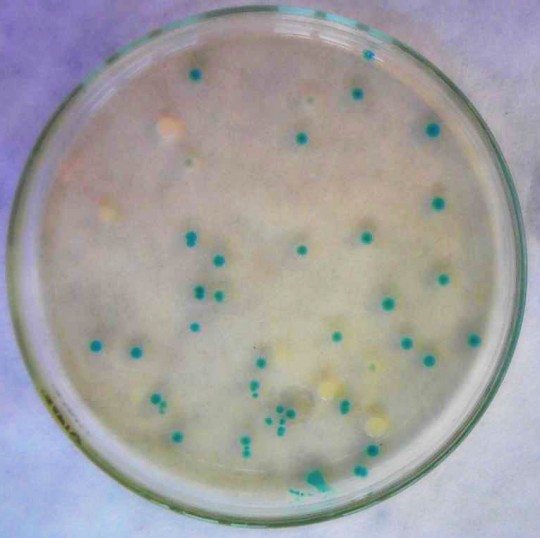
26. Růst na HiE.coli agaru
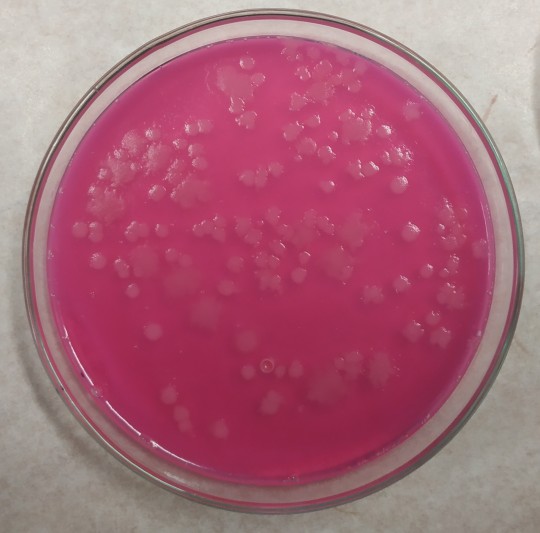
29. Růst Bacillus cereus na MYP

4.5
Základní stanovení mikroorganizmů
4.5.1
Stanovení celkového počtu mikroorganizmů
Souhrn
Jedná se o mezofilní aerobní a fakultativně anaerobní MO. Ukazují celkové mikrobiální osídlení mléka. Podle CPM se posuzuje jakost, trvanlivost a skladovatelnost, stupeň mikrobiální kontaminace a rekontaminace mléka, dodržování hygienických předpisů a dodržování technologických postupů. Nemá smysl stanovení používat ve výrobcích, kde byly použity čisté kultury mikroorganizmů.
Mezi nejčastěji zastoupené rody mikroorganizmů patří: rod Pseudomonas, Micrococcus, Bacillus, Escherichia, Enterobacter, Proteus, Lactobacillus, Pediococcus, Corynebacterium, Streptomyces, a další. Při tomto stanovení rostou na živné půdě i patogenní mikroorganizmy (Staphylococcus, Salmonella), je proto nutná zvýšená opatrnost při práci.
Metody stanovení – plotnová metoda. Metoda je vhodná pro vzorky, které obsahují více než 300 mikroorganizmů v 1 g nebo 30 mikroorganizmů v 1 ml. Je to metoda klasická.
Význam složek: G – glukóza – zdroj uhlíku a energie, T – trypton (pepton) – získává se enzymatickou hydrolýzou kaseinu, zdroj aminokyselin a polypeptidů, K – kvasničný extrakt – z autolyzovaných kvasnic, zdroj uhlíku, vitamínů, růstových faktorů, agar – zahušťovadlo, destilovaná voda.
Jednotlivé složky se odváží podle receptury a rozpustí v destilované vodě. Provede se úprava pH na 7,0 a živná půda se steriluje v autoklávu po dobu 15 minut při 121 °C.
Očkování se provádí se přelivem – 1 ml daného ředění na jednu Petriho misku, vždy tři po sobě jdoucí ředění, po dvou Petriho miskách. Kultivuje se i jedna Petriho miska s nalitou živnou půdou bez očkování – slouží jako kontrola živné půdy.
Misky se kultivují dnem vzhůru aerobně při teplotě 30 °C, 72 hodin. Stanoví se počet kolonií tvořících jednotky (KTJ). K výpočtu se použijí plotny, kde narostlo 10 až 300 kolonií.
Video 2. Stanovení CPM v syrovém mléce
4.5.2
Stanovení čeledi Enterobacteriaceae, koliformních bakterií a Escherichia coli
Souhrn
Jsou to indikátorové mikroorganizmy, udávají úroveň hygieny při výrobě, indikují možnost výskytu patogenních střevních mikroorganizmů.
Při stanovení se vychází z jejich základních vlastností – Enterobacteriaceae zkvašují glukózu, jsou odolné vůči žlučovým látkám, koliformní bakterie zkvašují glukózu a laktózu, jsou odolné vůči žlučovým látkám a Escherichia coli zkvašuje glukózu a laktózu, má enzym P-D-glukuronidázu, tvoří indol z tryptofanu, je odolný vůči žlučovým látkám (odolnost na brilantovou zeleň, laurylsulfát sodný).
4.5.2.1
Stanovení čeledi Enteroabecteriaceae
Definice
G- fakultativně anaerobní tyčinky, zkvašují glukózu s tvorbou plynu, mají negativní cytochromoxidázový test.
Význam složek: V – krystalová violeť, inhibitor G+ bakterií (hlavně enterokoků a stafylokoků), Č – neutrální červeň, indikátor pH (neutrální prostředí: oranžová, kyselé: červená, alkalické: žlutá), Ž – žlučové soli, inhibitor G+ bakterií a G-, které nežijí v zažívacím trakt, G – glukóza, specifický substrát, bakterie čeledi Enterobacteriaceae ho zkvašují za vzniku kyselého prostředí, projeví se zčervenáním v místě reakce.
Půda se očkuje přelivem, nedosouší se, rozlézavé kolonie se potlačí přelitím tenké vrstvy živné půdy nebo vodního agaru po ztuhnutí. Vhodný počet kolonií na Petriho misce je 10 – 150. Kultivuje se při 37 °C, 24 hod.
Vzhled kolonií: Povrchové: velké 1 – 4 mm, světle až jasně růžové nebo růžovofialové, vypouklé, lesklé, pod nimi nebo okolo sraženina (precipitace), vnitřní: menší, kulaté nebo diskovité, tmavší barvy.
Konfirmace kolonií: kolonie se přenesou kličkou frakcionovaně na živnou půdu MPA, po kultivaci 37 °C 24 hod se potvrdí negativní cytochromoxidázový test a provede se očkování vpichem do glukózového agaru, po kultivaci se potvrdí zkvašování glukosy zežloutnutím živné půdy (indikátor bromkresolpurpur).
+
Obr. 23. Růst na VČŽG
4.5.2.2
Stanovení koliformních bakterií
Definice
G- fakultativně anaerobní tyčinky, zkvašují laktózu s tvorbou plynu, mají negativní cytochromoxidázový test.
Živná půda: VČŽL (VRBL), selektivně diagnostická, steriluje se frakcionovaně. Význam složek je stejný jako u stanovení čeledi Enterobacteriaceae, L – laktóza, specifický substrát, koliformní bakterie ho zkvašují za vzniku kyselého prostředí, projeví se zčervenáním v místě reakce.
Vhodný počet kolonií na Petriho misce je 10 – 150. Kultivuje se při 30 °C, 24 hod.
Vzhled kolonií: povrchové velké 1 – 4 mm, světle až jasně růžové nebo růžovofialové, vypouklé, lesklé, pod nimi nebo okolo sraženina (precipitace), vnitřní kolonie jsou menší, kulaté nebo diskovité, tmavší barvy.
Další kultivační živné půdy: Endo-agar, Mc Conkey agar, Levinův agar, Chromocult.
+

Obr. 24. Růst na VČŽL
+
Obr. 25. Růst na Chromocultu
Konfirmace kolonií: kolonie se přenesou kličkou do tekuté živné půdy brilantová zeleň se žlučí a laktózou. Kultivuje se 30 °C, 24 hod. Pozitivní reakce je zákal, tvorba plynu.
4.5.2.3
Stanovení Escherichia coli
Definice
G- fakultativně anaerobní bakterie, zkvašují laktózu (enzym β-D-galaktosidáza), tvoří enzym β-D-glukuronidázu, tvoří indol z tryptofanu.
Živná půda: Chromocult, Fluorocult, Hicrome E. coli agar. Živné půdy obsahují substrát MUG (4-methyl-umbelliferyl-β-D-glukuronid), který je štěpen enzymem glukuronidáza za vzniku metabolitu, který vytváří specifické zabarvení – chromogenní živné půdy, nebo fluoreskuje po ozáření UV světlem (360 nm) – fluorogenní živné půdy.
Živná půda Chromocult obsahuje Salmon-Gal – koliformní bakterie ho štěpí za vzniku červené barvy, a obsahuje MUG – enzym β-D-glukuronidáza ho štěpí za vzniku modré barvy.
Očkuje se přelivem, vhodný počet kolonií 10 – 150, kultivace 37 °C, 24 hod.
Vzhled kolonií, hodnocení po kultivaci: červené kolonie – koliformní bakterie (mají enzym β-D-galaktosidáza, štěpí Salmon-Gal), sytě fialově modré – Escherichia coli (má oba enzymy, kombinace modré a červené barvy), světle modré – rod Salmonella (má enzym β-D-glukuronidáza, ale nemá enzym β-D-galaktosidáza), bezbarvé kolonie – ostatní zástupci čeledi Enterobacteriaceae, nemají žádný z enzymů).
+
Obr. 26. Růst na HiE.coli agaru
Konfirmace kolonií Escherichia coli: důkaz tvorby indolu z tryptofanu, tekutá živná půda, po kultivaci přídavek Kovacsova činidla – třešňově červené zbarvení.
+

Obr. 27. Konfirmační půdy
+

Obr. 28. Vyhodnocení konfirmace E.coli
Brilliance E. coli/coliform Selective Agar – umožňuje konfirmaci E. coli přímo na kultivační plotně. Purpurové kolonie – na plotnu je aplikováno Kovacsovo činidlo, kolonie E. coli se zbarví jasně třešňově červenou barvou.
Metodou se nestanoví patogenní kmen Escherichia coli 0157:H7, který nemá enzym β-D-glukuronidáza, tedy neštěpí MUG.
4.5.3
Stanovení počtu kvasinek a plísní
DRBC (Dichloran Rose Bengal chloramfenikol Agar) pro vzorky s aw více než 0,95 (mléko, zakysané výrobky, …).
DG18 Agar se používá pro stanovení počtu životaschopných osmofilních kvasinek a plísní v potravinách živočišného i rostlinného původu s aktivitou vody nižší než nebo rovnající se 0,95. Toto médium není vhodné pro posouzení sušených výrobků s aktivitou vody nižší než nebo rovnající se 0,60. Snížení aktivity vody v tomto médiu je dosaženo přidáním glycerolu (přibližně 18 %). Medium obsahuje také antimykotikum dichloran.
Význam jednotlivých složek: pepton – zdroj dusíku a vitamínů, glukóza – zdroj energie, dihydrogenfosforečnan draselný – pufrovací činidlo, síran hořečnatý (zinečnatý, měďnatý) – stimulace růstu hub a sporulace, dichloran – antimykotikum, inhibuje šíření hub a omezuje velikost kolonií, chloramfenikol – inhibuje růst bakterií, chlortetracyklin je širokospektrální antibiotikum, inhibující Gram-pozitivní a Gram-negativní bakterie, bengálská červeň – barvivo, agar – zpevňující činidlo, glycerol – zdroj uhlíku, snižuje vodní aktivitu.
Očkování roztěrem 0,1 ml připraveného vzorku na půdu v Petriho misce. Inkubace při 25 °C po dobu 2 a 5 dnů (DRBC) nebo 5 až 7 dnů (DG18).
Vyhodnocení: pro výpočet se použijí plotny obsahující méně než 150 kolonií.
Počet kvasinek a plísní v gramu nebo mililitru výrobku se vypočte podle obecného vzorce.
Další alternativní živné půdy
G glukóza, K kvasničný extrakt, CH chloramfenikol, Agar
Očkování přelivem, aerobní inkubace 25 °C, 5 dnů.
Ostatní živné půdy:
4.5.4
Stanovení dalších skupin mikroorganizmů
4.5.4.1
Stanovení koagulázopozitivních stafylokoků
Souhrn
Nejvýznamnějším zástupcem této skupiny mikroorganizmů je Staphylococcus aureus. Jeho pomnožení v potravinách je velmi nebezpečné, způsobuje otravy, které mohou být i smrtelné. Tvoří enterotoxiny, které koagulují krevní plazmu. Tvoří exopolysacharidy, a díky nim na povrchu látek (materiálů) velmi odolné biofilmy.
Zdrojem kontaminace mohou být nemocní lidé, hnisající rány, ale také vzduch, syrové maso, zařízení apod. Otrava se projevuje zvracením, průjmem, nevolností, … Obvykle rychle odezní, ale mohou být v závažných případech spojeny s dehydratací a šokem. Onemocnění může vyvolat toxin vyprodukovaný 105 – 106 KTJ v 1 g potraviny.
Definice
Staphylococcus aureus tvoří grampozitivní fakultativně anaerobní nesporulující koky, které vytvářejí typické polokulovité, citrónově žluté kolonie. Rozmnožuje se v rozmezí teplot 6,7 až 45,5 °C a toxiny produkuje během rozmnožování nebo krátce po něm.
Kultivační medium: agar podle Baird-Parkera (BP), očkování 0,2 ml roztěrem, aerobní kultivace při 35 nebo 37 °C, 48 h, jako inhibitor se používá teluričitan draselný a chlorid lithný.
Činnost Staphylococcus aureus, se projeví čirou zónou kolem kolonie s bílým prstencem vysrážených vápenatých a hořečnatých solí mastných kyselin v těsné blízkosti kolonie (došlo k rozkladu lipoproteinů a lipovitelininu žloutku v živné půdě).
Typické kolonie jsou černé, lesklé, vypouklé a jsou obklopeny zónou projasnění, která může být zčásti zakalená. V zóně projasnění v těsné blízkosti kolonií se může po inkubaci 24 h objevit opalescentní prstenec.
Atypické kolonie mají podobný vzhled, avšak zóna projasnění chybí (Staphylococcus epidermidis tvoří světlé kolonie bez projasnění, Bacillus a Proteus tvoří kolonie hnědé).
Agarová půda s králičí plazmou a fibrinogenem (RPF agar) – koaguláza pozitivní stafylokoky na této půdě vytvářejí černé, šedé nebo dokonce bílé malé kolonie obklopené zónou precipitace, která indikuje koagulázovou aktivitu.
K detekci jsou běžně používány imunologické metody: reverzní pasivní latexová aglutinace, ELISA, ELFA.
Metody využívané při konfirmaci, identifikaci a typizaci: tvorba hemolýzy na krevním agaru, reakcí s fibrinogenem králičí plazmy (tvorba chuchvalců, sraženin nebo úplné ztuhnutí plazmy ve zkumavce), průkaz přítomnosti vázané koagulázy (clumping faktor – Dryspot Staphytest Plus).
Další metody: např. PCR s využitím specifických primerů lze detekovat a identifikovat druh Staphylococcus aureus, i prokázat přítomnost genů kódujících tvorbu stafylokokových enterotoxinů a dalších faktorů virulence a také genů kódujících rezistenci k antimikrobiálním látkám (např. MRSA kmeny).
4.5.4.2
Stanovení Listeria monocytogenes
Definice
Listeria monocytogenes je patogenní pro člověka i pro zvířata, je to G+ krátká tyčinka, fakultativně anaerobní, nesporotvorná. Buňky se vyskytují se jednotlivě nebo ve dvojicích, mohou tvořit řetízky. Infekční dávka je asi 108 KTJ, u osob s oslabenou imunitou je 102 – 103 buněk v 1 g potraviny. Přenos je alimentární cestou.
Zdrojem může být např. syrové maso a vařené masné výrobky, syrová zelenina, ryby (hlavně uzené), syrové mléko a mléčné výrobky (sýry zrající pod mazem, sýry s plísní), lahůdkářské výrobky.
Vyvolává horečku, bolesti hlavy, nevolnost, zvracení, septikémii, meningitidu, encefalitidu, potraty apod., podle typu onemocnění.
Pro kultivaci se používají živné půdy obsahující látky inhibující růst doprovodné mikroflóry (např. chlorid litný, akriflavin, polymyxin), dále eskulin, který listerie štěpí na eskuletin, jenž s citrátem železitoamonným tvoří hnědočerný barevný komplex.
Při průkazu Listeria monocytogenes se vzorek inokuluje do tekuté selektivní půdy pro primární pomnožení – poloviční bujón podle Frasera (poloviční FB médium) při 30 °C 24 h. Získaná kultura se přeočkuje do tekuté selektivní půdy pro sekundární pomnožení – bujón podle Frasera (FB médium). Z primárního i sekundárního pomnožení se provádí vyočkování na dvě pevné selektivní půdy – agar pro listerie podle Ottavianiho a Agostiho (ALOA agar) a kteroukoli jinou selektivní půdu (např. PALCAM agar) při 37 °C 24 h. Nakonec se provede konfirmace vybraných suspektních kolonií.
Listeria monocytogenes na ALOA agaru se projeví modrozelenou barvou kolonií (aktivita enzymu galaktosidáza) a výraznou zónou precipitace (aktivita enzymu fosfolipáza C).
Konfirmace vybraných kolonií: API Listeria test, Rapid L. mono test, CAMP test.
Alternativní způsoby detekce listerií v potravinách – PCR, LCR, hybridizace, amplifikace specifických úseků RNA, ELFA, ELISA nebo imunochromatografická technika na membráně, Imunosenzor, apod.
4.5.4.3
Stanovení Cronobacter sakazakii (Enterobacter sakazakii)
Definice
G- tyčinka, fakultativně anaerobní, nesporotvorná, peritrichální bičíky. Na neselektivních půdách tvoří dva typy žlutých nebo bezbarvých kolonií (suché nebo mukoidní, vroubkované kolonie, nebo jenom hladké).
Souhrn
Cronobacter sakazakii je běžnou součástí střevní mikroflóry teplokrevných zvířat, dále se vyskytuje ve vodě, půdě a na zelenině. Mohou ho přenášet mouchy nebo hlodavci. Nachází se na suchých místech. V potravinách se vyskytuje především v sušené dětské výživě, dále i v cereáliích, luštěninách, ovocných a zeleninových salátech, masných výrobcích, syrovém mléce, apod.).
Napadá hlavně oslabené jedince a novorozence. Způsobuje sepsi, meningitidu a nekrotizující enterokolitidu. U dospělých jedinců vyvolává zánět spojivek, zánět žlučovodu a močových cest, infekce ran, zápal plic. Infekční dávka je asi 103 KTJ na 1 g potraviny.
Stanovení Cronobacter sakazakii v potravinách se provádí kvalitativně. Ke kultivaci se používají neselektivní pomnožovací média a dále selektivní tekuté půdy obsahující látky inhibující růst doprovodné mikroflóry (např. vankomycin), k vlastní izolaci se používají chromogenní půdy. Suspektní kolonie jsou konfirmovány na základě tvorby žlutého pigmentu a vybraných biochemických reakcí.
Vzorek se nejdříve homogenizuje v pufrované peptonové vodě (PPV) 37 °C 16 – 20 h. Kultura se pak přeočkuje (0,1 ml) do selektivní tekuté půdy – modifikovaná laurylsulfát tryptózová půda s vankomycinem (mLST médium) 44 °C 24 h. Ze selektivního pomnožení se provede vyočkování na pevnou chromogenní půdu – Enterobacter sakazakii izolační agar (ESIA agar) 44 °C 24 h, nebo jinou chromogenní půdu poskytující shodné výsledky.
U vybraných kolonií se provede konfirmace – posouzení tvorby žlutého pigmentu a biochemické aktivity (oxidáza, utilizace aminokyselin, fermentace cukrů, hydrolýza citrátů). Metody využívané při konfirmaci, identifikaci a typizaci – ENTERO test, molekulárně biologické metody (např. sekvence DNA, PFGE).
4.5.4.4
Stanovení Bacillus cereus
Definice
Sporulující G+ tyčinka, pohyblivá, eliptické spory umístěné centrálně, nemění tvar tyčinky, fakultativně anaerobní.
Souhrn
Velmi rozšířený v přírodě – půda, rostliny, potravinářské suroviny cereálního původu. Technologicky i hygienicky rizikový kontaminant potravinářské výroby, psychrotrofní kmeny znehodnocují potraviny při skladování.
Způsobuje intoxikaci potravin – produkuje několik toxinů, některé jsou vysoce termostabilní. Příznaky otrav – bolesti břicha, průjem, nevolnost a zvracení; ohroženy jsou hlavně malé děti, rekonvalescenti a staří lidé. Zdrojem otrav jsou nejčastěji předem připravované a nesprávně uchované pudinky, vařená rýže, vařené maso a masné výrobky, polévky, zeleninové pokrmy a jiná jídla obsahující sacharidy, pasterované a sušené mléko. Enzym lecithináza rozkládá lecithin na jedovatý lysolecithin a fosfocholin. Intoxikace je při výskytu 106 – 107 buněk/g stravy dospělých a 104 – 105 buněk/g stravy dětí.
Stanovení: využívá se selektivně diagnostická živná půda MYP (žloutkový agar s polymyxinem B a fenolovou červení). Význam složek: M mannitol – alkoholový cukr, není zkvašován, Y vaječný žloutek, žloutková emulse (yolk) – zdroj lecithinu, při reakci vzniká precipitace, P polymixin B – antibiotikum, inhibitor, potlačuje doprovodnou mikroflóru, fenolová červeň – indikátor pH (kyselé – žlutá, neutrální – červená), další složky – masopeptonový extrakt, pepton, NaCl, agar, voda.
Vzorek se očkuje na předsušenou plotnu živné půdy (30 min při 50 °C) 0,1 ml (0,2 ml) vzorku nebo ředění roztěrem paralelně do dvou misek, nechá se vsáknout 15 min. Inkubace 30 °C 18 až 24 hodin aerobně. Počítají se misky s méně než 150 koloniemi. Typické kolonie jsou drsné, suché, růžové, okrouhlé, obklopené prstencem bílého až narůžovělého precipitátu (tvorba lecitinázy), půda se zabarví červeně (mannitol není zkvašován), kyselinotvorné bakterie mohou potlačit červenání – konfirmace kolonií s precipitací.
Konfirmace: z každé plotny se vybere po pěti koloniích. Kultivace v glukózovém agaru s bromkresolpurpurem (30 °C 18 až 24 hodin) – žluté zbarvení celého sloupce. Voges – Proskauerova reakce – inkubace 30 °C 24 hodin, pozitivní reakce – eosinově růžové zbarvení živné půdy (1 ml po kultivaci v VP testu do zkumavky + 0,2 ml 40% NaOH + 0,6 ml roztoku α-naftolu + několik krystalků kreatinu, protřepat, počkat 1 hodinu), z dalších metod – redukce dusičnanů, mikroskopický preparát – tvorba spor.
+
Obr. 29. Růst Bacillus cereus na MYP
4.5.4.5
Stanovení Clostridium perfringens
Definice
Anaerobní, nepohyblivé sporulující G+ tyčinky, vřetenovitě nebo paličkovitě rozšířené, krátké řetízky, spory jsou umístěny subterminálně.
Souhrn
Způsobuje intoxikaci potravin – enterotoxin (6 sérotypů, nejčastěji A) vzniká při sporulaci většinou až v tenkém střevě, otravy při výskytu 106 – 107 mikroorganizmů/g potraviny, příznaky 6 až 24 hodin po požití, bolesti břicha, průjmy, zvracení, (odezní za 1 – 2 dny) nebo smrt. Kromě intoxikace dochází k nekrotizujícím změnám sliznice střev (typ A – gangréna (sněť), typ C – nekróza (odumření tkáně) a enteritis (zánět).
Velmi hojný v půdě, v prachu, ve výkalech. Infikuje vodu, syrové maso, drůbeží maso, mléko, přežívá nedostatečné chemické i tepelní čištění, je hydrofilní, odolný vůči vyschnutí.
Stanovení Clostridium perfringens na živné půdě TSC (tryptososiřičitanový agar s cykloserinem).
Očkování přelivem, kultivace dnem vzhůru v anaerostatu 18 až 20 hodin při 37 °C. Typické kolonie – černé, čočkovité, vatovité (chomáčkovité) kolonie od průměru 2 mm.
Konfirmace: vybere se deset typických kolonií, které se kultivují na základním mediu bez cykloserinu. Poté se zjišťuje pohyblivost vpichem do sloupce živné půdy, anaerobní kultivace 24 hodin 37 °C (bez pohybu, růst jen v linii vpichu); redukce dusičnanů – anaerobní kultivace 24 hodin 37 °C, přidá se činidlo na přítomnost NO2- 0,5 ml (zčervenání); zkvašování laktózy a ztekucování želatiny – půda s fenolovou červení, anaerobní kultivace 24 hodin 37 °C (zežloutnutí půdy a ztekucení půdy); mikroskopický preparát – Gramovo barvení, přítomnost spor.
4.5.4.6
Stanovení rodu Salmonella spp.
Definice
G- fakultativně anaerobní, nesporulující tyčinky, zkvašují glukózu, jsou laktóza negativní, kataláza pozitivní a oxidáza negativní. Většina salmonel (s výjimkou S. typhi) využívá jako zdroj uhlíku citráty, dekarboxylují lyzin, arginin a ornitin, produkují sirovodík.
Souhrn
Všechny salmonely běžně významné pro člověka patří do prvního druhu Salmonella enterica a většinou do poddruhu Salmonella enterica subsp. enterica.
Zoopatogenní salmonely jsou v současné době spolu s kampylobaktery nejčastějšími původci bakteriálních střevních nákaz. Způsobuje střevní infekci bez komplikací. Inkubační doba je 12 hodin až 5 dnů, nejčastěji 24 – 48 hodin. Charakteristické jsou průjmy, zvracení a horečka. Infekční dávka je 105 – 108 KTJ v 1 g potraviny, ale může být i nižší, zejména u dětí, starších osob s oslabenou imunitou.
Salmonely se nachází v zažívacím traktu ptáků, plazů, hmyzu, zvířat a člověka. Jsou vylučovány s fekáliemi a kontaminují životní prostředí a potraviny, zejména syrové maso (nejčastěji drůbeží a vepřové), cukrářské a lahůdkářské výrobky, syrové mléko, vejce apod.
Stanovení salmonel v potravinách se provádí kvalitativně. Ke kultivaci se používají neselektivní pomnožovací média (pufrovaná peptonová voda (PPV) 37 °C, 20 h). Dále pomnožení ve 2 tekutých selektivních půdách – Rappaport Vassiliadis sója médium (RVS médium) a Mueller-Kauffman tetrationát novobiocin médium (MKTTn médium) 24 h, 41,5 °C. Vyočkování se provádí na dvě pevné selektivní půdy – agar s xylózou, lyzinem a deoxycholátem (XLD agar) 24 h, 37 °C a selektivní půdu např. agar s fenolovou červení a brilantovou zelení (BR agar) nebo chromogenní agar pro stanovení salmonel (např. Rambach agar, IRIS Salmonella agar).
Biochemická konfirmace – růst na TSI agaru, průkaz štěpení močoviny, průkaz lyzindekarboxylázy, průkaz β-galaktosidázy, VP test a průkaz tvorby indolu. Je možné použít komerční identifikační soupravy (např. ENTEROtest, API test). Po biochemické identifikaci následuje sérologická konfirmace a sérotypizace, která je zaměřena na průkaz somatických (O) a bičíkových (H) antigenů, příp. i antigenů povrchového pouzdra (Vi) aglutinační reakcí.
Další metody stanovení salmonel: ELISA a ELFA, imunochromatografické detekční sety, metody PCR (např. multiplex či real-time PCR, RFLP-PCR), využít lze i metodu pulzní gelové elektroforézy (PFGE).
4.5.4.7
Stanovení enterokoků
Definice
Ukazatel čerstvého fekálního znečištění, G+ bakterie, signalizuje nedostatečnou chloraci, riziko výskytu virů (viry odolné proti chloru, nebezpečí hepatitidy A), ve vodě se nemnoží, ale přežívají.
Živné médium: Agar dle Slanetz-Bartleyové (pepton, kvasničný extrakt, glukosa, K2HPO4, agar, selekce přítomnosti 4% NaN3, 1% TTC – je redukován na červený formazan)
Očkování roztěrem 0,1 ml, inkubace při 37 °C 44 hodin.
Enterokoky na půdě Slanetz-Bartleyové vytvářejí kolonie 1 – 2 mm v průměru, hnědočerveně až růžově zbarvené, zpravidla okrouhlé, hladké a lesklé. Půda v jejich okolí je zbarvena.
Z každé misky se vybere 5 kolonií, které se podrobí konfirmačním testům – hydrolýza eskulinu a průkaz katalázy.
Kolonie se přeočkují na žluč-eskulin azidový agar, pozitivní rostou v tmavě hnědých až černých drobných koloniích nebo zbarvují dvorec kultivační půdy černě (do 24 hod. inkubace při 44 °C). Katalázový test s 3% H2O2 – tvorba bublin kyslíku indikuje kataláza-pozitivní mikroorganizmy.
Glukóza je v živné půdě zdroj
Kvasničný extrakt je v živné půdě
Kultivace při stanovení CPM je
Stanovení bakterií čeledi Enterobacteriaceae provádíme na živné půdě
Konfirmace koliformních bakterií se provádí v živné půdě
Escherichia coli
Na živné půdě s MUG má Escherichia coli kolonie barvy
Pro stanovení počtu kvasinek a plísní používáme živnou půdu
Dichloran v živné půdě působí jako
Selektivně diagnostická živná půda MYP obsahuje zdroj lecitinu
Clostridium perfringens je bakterie
Enterokoky signalizují